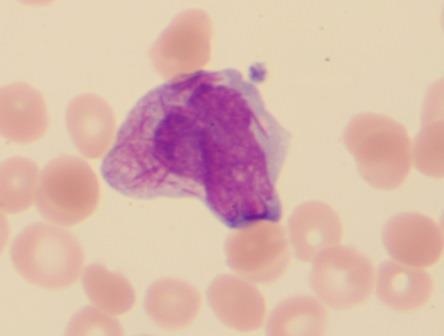
Abb. 3: Blast mit multiplen Auerstäbchen (Fagottzelle) bei...

Von der Morphologie zum „Whole Genom Sequencing“

Die labormedizinische Basis des Hämatologen war lange Zeit die morphologische Zellanalyse, sowohl für die Beurteilung von pathologischen Veränderungen des „roten" Blutbildes als auch der Verteilung und der morphologischen Veränderungen der „weißen" Zellen des Blutes, den Leukozyten.
Die mikroskopische Erstellung eines sogenannten Differentialblutbildes aber auch die Beurteilung des Gehaltes und der Verteilung von Blutzellen im Knochenmarksblut war bisher die Domäne der morphologisch ausgebildeten Laborärzte und der in der hämatologischen Diagnostik arbeitenden medizinisch technischen Assistentinnen.
Diese klassische morphologische Diagnostik ist zeit- und personalaufwendig und damit auch kostenintensiv. Sie erfordert zudem ein hohes Maß an Erfahrung und Konzentration. Da in der Regel nur 100 Zellen differenziert werden, sind die Differenzierungsergebnisse insbesondere bei nicht so häufigen Zellpopulationen (Monozyten, Basophile, Eosinophile) aber auch pathologischen Zellen nur mit Vorbehalt zu bewerten.
Hämatologische Analyseautomaten
Seit die Einführung von hämatologischen Analyseautomaten die Analyse einer um Größenordnungen höheren Zellzahl ermöglicht, sind zwar die Ergebnisse statistisch gesehen exakter und vor allen Dingen auch besser reproduzierbar, allerdings kranken die automatischen Differenziergeräte immer noch daran, dass die der maschinellen Differenzierung zugrunde liegenden Entscheidungskriterien oder Entscheidungsalgorithmen der Geräte nicht transparent sind und es sich um Näherungen und Schätzungen auf der Basis einer Vielzahl von mehreren gleichzeitig anfallenden Informationen aus der Einzelzellanalyse handelt, wodurch letztlich die Zelle klassifiziert und zugeordnet wird.
Die hämatologischen Analyseautomaten werden technologisch und methodisch kontinuierlich weiterentwickelt und haben auch aufgrund der heute verfügbaren Rechnerkapazitäten durchaus schon eine respektable Zuverlässigkeit erreicht.
Allerdings müssen so genannte „geflaggte" beziehungsweise durch Warnhinweise identifizierte Proben mit der klassischen morphologischen Methode „manuell" oder besser gesagt mikroskopisch nachdifferenziert werden. Dieses stellt rein personell eine erhebliche Herausforderung an das Labor dar.
Bei der digitalisierten computergestützte automatisierten Mikroskopie werden - wie bei der klassischen morphologischen Methode standardisiert angefertigte und gefärbte Ausstrichpräparate in eine Mikroskopierhalterung eingespannt. Ein motorgetriebenes Mikroskop mit digitalem Fotoaufsatz scannt dann den Ausstrich und speichert alle erfassten kernhaltigen Zellen als Einzelzellbild ab.
Mit Hilfe einer entsprechenden Software, die charakteristische Zellstrukturen erfasst, werden die Zellen klassifiziert und bestimmten Zellkategorien zugeordnet. Vorteil dieser Methode ist, dass der Mikroskopiervorgang und die primäre Zuordnung einen nur geringen Personalaufwand erfordern und damit z. B. im Bereitschaftsdienst des Labors durchaus hilfreich ist, insbesondere wenn die MTLA an anderen Arbeitsplätzen gebunden ist.
Nachteilig ist, dass auch bei dieser Methode im Vergleich zu den durchflusszytometrischen Verfahren nur relativ wenige Zellen (100 - 400) differenziert werden können und dass die Zellzahlen insbesondere bei hohen oder auch sehr niedrigen Gesamtzellzahlen in der Regel einem repräsentativen Verteilungsmuster nicht zwingend entspricht.
Die „digitalisierten" Zellen müssen allerdings bezüglich ihrer Zuordnung noch einmal visuell am Bildschirm kontrolliert und gegebenenfalls durch „Mouseclick" und Verschiebung in eine andere Kategorie neu klassifiziert werden.
Die Diagnostik von Hämoblastosen aber auch von Lymphomen und die Abtrennung der reaktiven Veränderungen von neoplastischen Veränderungen insbesondere bei Lymphozytosen sind heute weniger das Feld der Morphologie als vielmehr der durchflusszytometrischen Bestimmung von immunphänotypischen Oberflächenmarkern der Zellen.
Die Leukämiediagnostik war früher eine Domäne der hämatologischen Morphologie. Auf der Basis von zellulären Strukturen (Kern/Plasmarelation, Basophilie des Zytoplasmas, Zellgröße, Nukleoli im Kern, Nachweis von auskristallisierten plasmatischen Granula, den sog. Auerstäbchen) und der Anfärbbarkeit von Zellstrukturen durch spezielle Farbstoffe, wurde vor gut 50 Jahren die FAB-Klassifikation der Leukosen eingeführt. Diese Klassifikation wird in der morphologischen Diagnostik zwar noch häufig verwendet, ist inzwischen aber infolge der diagnostischen Ergänzung durch Chromosomenanalyse und Verwendung von speziellen Oberflächenmarkern zu einer sehr viel subtileren Einteilung weiterentwickelt worden. Unabhängig von den modernen Methoden zur Subtypisierung ist die Orientierung an morphologischen Kriterien noch eine wesentliche Grundvoraussetzung der Diagnostik. Die neue Einteilung der Leukämie basiert zu einem großen Teil auf der Analyse von Chromosomenaberrationen. Zusätzlich fließen in die neue Klassifizierung Oberflächenmarkeranalysen ein.
Moderne methodische Verfahren wie Massenspektrometrie und „Proteomics" unterstützen einerseits die Diagnose, andererseits erlauben sie potenzielle Rückschlüsse auf der Erkrankung zugrunde liegenden Pathomechanismen.
Ein wesentliches Ziel der Leukämiediagnostik ist der Nachweis bzw. Ausschluss von Resttumormasse (minimal residual disease), wobei insbesondere molekulargenetische Methoden (real-time PCR) zur Anwendung kommen.
Herausforderung der Morphologen
Eine für den Morphologen grundsätzliche Herausforderung ist die Differenzierung von reaktiv oder neoplastisch veränderten Lymphozyten. Auch dem erfahrensten Untersucher gelingt die morphologische Zuordnung nicht in jedem Fall: zu groß ist die morphologische Variabilität selbst der „normalen" Lymphozyten.
Auch wenn es automatisierte bzw. apparative analytische Ansätze zur Differenzierung neoplastischer und reaktiver Lymphozyten auf Basis der chemischen Membranbeschaffenheit und der Menge an fluoreszierenden biologischen Material in der Zelle gibt, so bleibt die tatsächliche Zuordnung der Zellen zu den verschiedenen Lymphomentitäten der Analyse spezifischer Oberflächenmarker überlassen.
Ergänzend werden auch bei den Lymphomen zunehmend zytogenetische und molekularbiologische bzw. molekulargenetische Untersuchungen ergänzend in die Diagnostik eingebracht.
Ziel einer sich von der klassischen Morphologie zu einer molekularen Differenzierung von Hämoblastosen und lymphatischen Systemerkrankungen entwickelnden hämatologischen Diagnostik ist einerseits die bessere Stratefizierung im Rahmen von Therapiestudien und andererseits die Individualisierung der Therapie um ein optimales Ergebnis der Behandlungsbemühungen sicherzustellen.
Die moderne Leukämie- und Lymphomdiagnostik basiert zunehmend auf genetischen und molekular-genetischen Verfahren. Durch die Einführung der Sequenzierung des Gesamtgens macht die hämatologische Diagnostik einen regelrechten Quantensprung: Dieses „Whole Genom Sequencing" - vor Jahren noch höchst kostenaufwendige Methode - wird sicherlich in naher Zukunft zu einer Routinemethode werden. Allerdings sind die hohen Investitionen für die notwendigen apparativen Ausstattungen im Verhältnis zu den im Routinelabor relativ weniger häufigen Hämoblastosen und Lymphome unwirtschaftlich. Daher wird diese zukunftsgerichtete Diagnostik dem hämatologischen Speziallabors mit einem überregionalen Einsenderklientel vorbehalten bleiben.
Moderne Leukämiediagnostik
Zytomorphologie
- (Ausstrich nach Pappenheim, Peroxidase- und Esterasereaktion, Eisenfärbung)
Multiparameter-Immunphänotypisierung
- (Obligat in der AML-, ALL- und CLL-Diagnostik; Bestimmung der Bestimmung der minimalen Resterkrankung [MRD] und damit der Prognose)
Chromosomenanalyse
- (Metaphase-Zytogenetik m.H. der Bänderungstechnik)
Fluoreszens-in-situ-Hybridisierung (FISH)
- (Hybridisierung von DNA-Sondenukturen, die spezifische chromosomale Strukturen identifizieren; Untersuchung auch an Interphasekernen möglich; Verlaufskontrollen, Nachweis von Resterkrankung)
Realtime-PCR
- (Nachweis minimaler Resterkrankung unter und nach der Therapie)
Genexpression und Proteomics
- (im Forschungs- und Entwicklungsstadium)
Whole Genome Sequencing
Meist gelesen

Klinikum Wolfsburg: Neue Leitung für die Urologie
Prof. Dr. med. Florian Fuller übernimmt Chefarztposition – Dr. Armin Leitenberger verabschiedet sich nach knapp 20 Jahren in den Ruhestand.

Universal Gloving: ein Problem für die Hygiene und die Umwelt
Um Erregerübertragungen und Hautirritationen zu vermeiden sind Einmalhandschuhe indikationsadäquat und nachhaltig zu nutzen.

Hygiene(mängel) – zwischen Verantwortung, Haftung und Strafbarkeit
Konsequente Umsetzung der Hygienevorschriften, regelmäßige Kontrollen des Hygieneplans und laufende Fortbildung können das zivil- und strafrechtliche Risiko erheblich verringern.

„Die ePA zwischen Sanktionsdruck und Klinikrealität“
Prof. Dr. Henriette Neumeyer im Interview zur ePA

"Die Quellensuche war eine Herausforderung“
Am Universitätsklinikum Frankfurt am Main trat 2023 eine systemische P. aeruginosa Trinkwasserkontamination auf. Als wahrscheinliche Kontaminationsquelle wurde ein Wasserzähler identifiziert.





